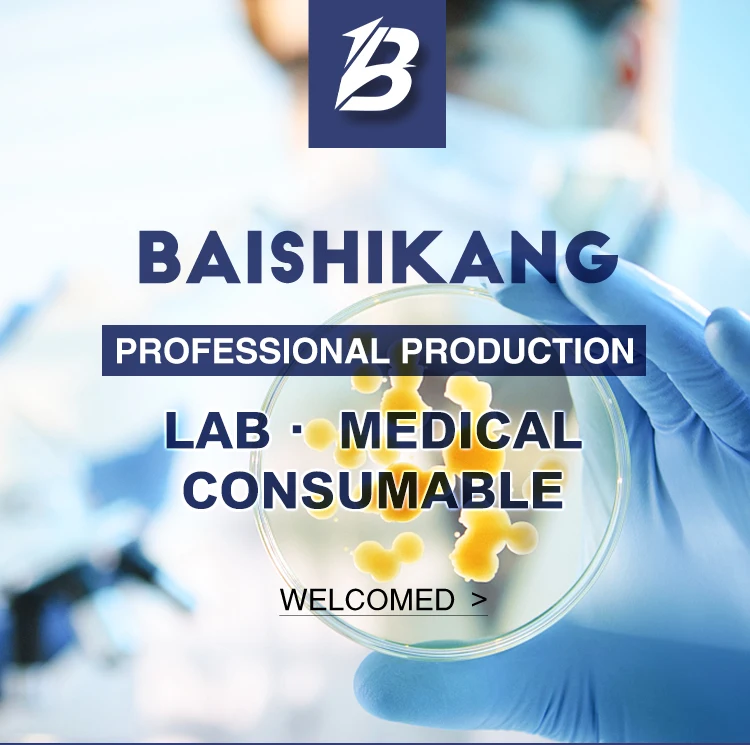

Factory wholesale disposable sputum cup with lid for aseptic sampling and collection of sample specimens
- Category: Lab Supplies >>>
- Supplier: Jiangsu Baishikang Import & Export Co. Ltd.
Share on (10000005606534):
Product Overview
Description

Product parameters
Product Name | Disposable Plastic Medical Test Sample Cup Urine Container |
Capacity | 30ml, 40ml, 60ml, 90ml, 100ml, 120ml, 150ml |
Material | Polypropylene(PP) |
Brand | Baishikang |
Customized | OEM & ODM |
Package | Individual Package Or Bulk Package |
Sample | Free sample |
Sterile | EO Gas Sterile |
Products Display
Company Profile




Certifications

Logistics & Payment

FAQ
1.About Samples:
1) Stock item: samples can be sent out immediately. And for shipping charge, if you are new customer, just need to provide us Fedex, DHL or UPS account number for freight collect. If you are our old customer, we can send exclude the certain item.
1) Stock item: samples can be sent out immediately. And for shipping charge, if you are new customer, just need to provide us Fedex, DHL or UPS account number for freight collect. If you are our old customer, we can send exclude the certain item.
2. About Price:
1) Please contact us for further detailed information, such as quantity, capacity, packing details.
1) Please contact us for further detailed information, such as quantity, capacity, packing details.
3. About Shipment:
1) FOB: Please tell us your forwarder's information.
2) CIF: We can arrange ship by sea or air, you just need to tell us seaport or airport.
3) DDP: Some countries accept DDP term, please contact us for detailed information.
1) FOB: Please tell us your forwarder's information.
2) CIF: We can arrange ship by sea or air, you just need to tell us seaport or airport.
3) DDP: Some countries accept DDP term, please contact us for detailed information.
4. About Payment:
1) Various choice: Credit card, T/T, L/C, Western union, Paypal, Alipay, etc.
1) Various choice: Credit card, T/T, L/C, Western union, Paypal, Alipay, etc.
5. About MOQ:
1) Depend on products, usually one carton.
1) Depend on products, usually one carton.
6. About OEM & ODM:
1) Both OEM and ODM are available. We can customize according to your requirement.
1) Both OEM and ODM are available. We can customize according to your requirement.

We Recommend
5L digital hot plate magnetic stirrer with hotplate
US $19.90-$50.00
JOAN Laboratory Filtration Apparatus 1000ml With 300ml Funnel
US $16.00-$25.00
New Arrivals
New products from manufacturers at wholesale prices



















